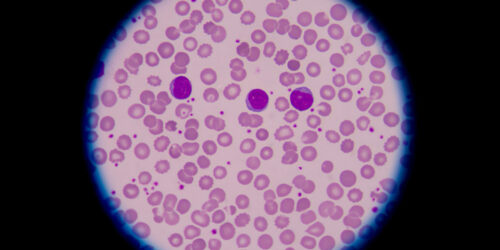
Types of blood disorders you must know about

Types of blood disorders you must know about
A blood disorder is a condition that impacts one or more parts of the blood and prevents it from functioning correctly. These parts are red blood cells, white blood cells, platelets. All these cell types form in the bone marrow, a soft tissue located inside one’s bones. There are various types of blood disorders, and their symptoms depend on the type.
Read More 



